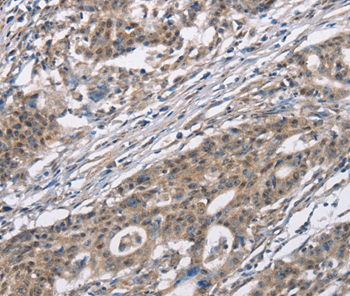
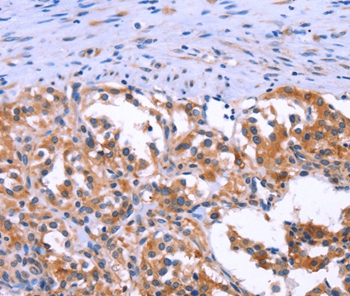

-
分类: 科研抗体货号: P42885别名: K6B; PC2; CK6B; CK-6B; KRTL1应用: IHC反应种属: Human
-
分类: 科研抗体货号: P42898别名: OAT3应用: WB,IHC反应种属: Human
-
分类: 科研抗体货号: P42884别名: PGA3; PGA4应用: WB,IHC反应种属: Human
-
分类: 科研抗体货号: P42897别名: NTN应用: IHC反应种属: Human
-
分类: 科研抗体货号: P42920别名: CDC2L2; CDC2L3; p58GTA; PITSLRE; CDK11-p46; CDK11-p58; CDK11-p110 / p58; PK58; CDK11; CLK-1; CDC2L1; p58CLK-1; CDK11-p46; CDK11-p58; p58CDC2L1; CDK11-p110应用: WB,IHC反应种属: Human,Mouse
-
分类: 科研抗体货号: P42895别名: ASY; NSP; NOGO; NOGOC; RTN-X; NOGO-A; NSP-CL; Nogo-B; Nogo-C; RTN4-A; RTN4-C; RTN4-B1; RTN4-B2; NI220/250; Nbla00271; Nbla10545应用: WB,IHC反应种属: Human,Mouse
-
分类: 科研抗体货号: P42918别名: CACH3; CACN4; PASNA; SANDD; Cav1.3; CCHL1A2; CACNL1A2应用: IHC反应种属: Human
-
分类: 科研抗体货号: P42894别名: DRCC1; MUC-13应用: IHC反应种属: Human
-
分类: 科研抗体货号: P42915别名: p85; MPPH; P85B; p85-BETA应用: WB,IHC反应种属: Human,Rat
-
分类: 科研抗体货号: P42893别名: DOG1; TAOS2; ORAOV2; TMEM16A应用: WB,IHC反应种属: Human,Mouse

鄂公网安备42018502007531号
鄂公网安备42018502007531号

